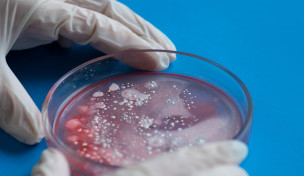
Kulturen in einer Petrischale

Image
Fragen & Antworten
-
Stand:
Ist Dextrose das Gleiche wie Zucker? Und was ist eigentlich ein Proteinpudding? Das Team von Lebensmittelklarheit beantwortet im Expertenforum Ihre Fragen.
Hier finden Sie die Antworten auf Verbraucheranfragen an Lebensmittelklarheit.
Ergebnisse Filtern: